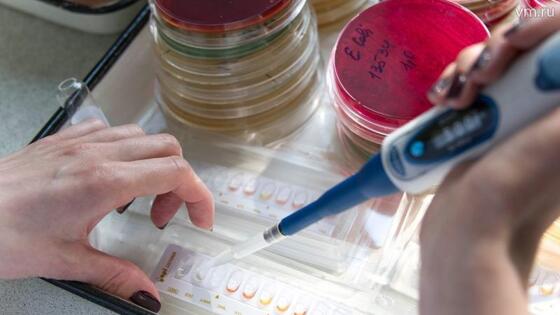

Москвичам расскажут о сдаче анализов в парке «Зарядье»
Лекция «Зачем сдавать анализы» состоится 18 апреля на территории павильона «Заповедное посольство» в парке «Зарядье».
Во время образовательного мероприятия москвичи узнают много полезной информации по указанной теме. Лекцию для всех желающих прочитает руководитель центра лабораторной диагностики городской клинической больницы № 67 имени Ворохобова Ольга Калачева.
Она расскажет столичным жителям не только о том, зачем сдавать анализы. Ольга Калачева сообщит, как готовиться к их сдаче, что они помогают установить. Кроме того, медицинский специалист во время лекции проинформирует о разных видах анализов и развитии этого направления.
- Лучше, чтобы анализы проводились по направлению лечащего врача. В ином случае ответственность за их интерпретацию лежит на самом пациенте. Не менее важно, чтобы лаборатория была должным образом сертифицирована, - приводит слова Ольги Калачевой официальный сайт мэра Москвы.
Начало лекции в 19:00. Для посещения необходима предварительная регистрация.